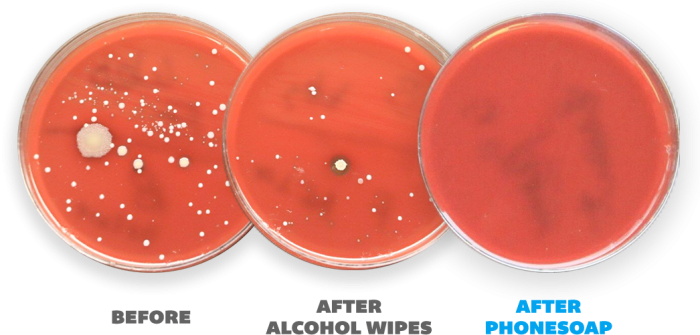
Alcohol Isn't the Solution!

10 Valentine's Day Gifts for Her
10 Valentine's Day Gifts for Her
In the past, Valentine’s Day gifts were almost exclusively exchanged between those in a relationship. Now, it’s much more common to give ...
 How to Celebrate Galentine's Day
How to Celebrate Galentine's Day
Valentine’s Day: You either love it or hate it. When you’re in a relationship, it can be exciting to shower your significant other with ...
 5 V-Day Movies You Need to Watch
5 V-Day Movies You Need to Watch
Calling all movie lovers! Get your popcorn. Get your chocolates. Get your blankets. Because we've got the top 5 Valen...
 How to Celebrate Valentine’s Day When You’re Single
How to Celebrate Valentine’s Day When You’re Single
If you wanted to ask me the question, “Author, what’s the most depressing thing you’ve ever seen?” (and who wouldn’t ...
 How to Survive a Long Distance Relationship
How to Survive a Long Distance Relationship
We've all heard that one saying, "Distance makes the heart grow fonder." And that may be true, but that doesn't make long distance relati...
 Keep Your Home Safe from the Flu
Keep Your Home Safe from the Flu
Wanna hear my super-duper hilarious (read: very bad) stand-up joke? “There’s a reason FLU rhymes with BOO, am I right?!” Honestly, very u...
 How to Keep Things Clean When You're Sick
How to Keep Things Clean When You're Sick
The COVID-19 pandemic has taught us a LOT of things and we've really had to adapt. One good thing is the habits and practices we've learn...
 How Do I Clean My Phone?
How Do I Clean My Phone?
How to Clean Your Phone So you need to find a safe and effective way to clean your phone? Well, you've come to the ...
 How to Clean a Phone Screen
How to Clean a Phone Screen
As you go through your daily routine, you will touch shopping carts, gym equipment, door handles, elevator buttons, ...
Alcohol Isn't the Solution!
Alcohol Isn't the Solution!
PhoneSoap vs. Alcohol Wipes People use a variety of ways to quickly “clean” their phone; corner of your shirt, water, wipes, or better ye...